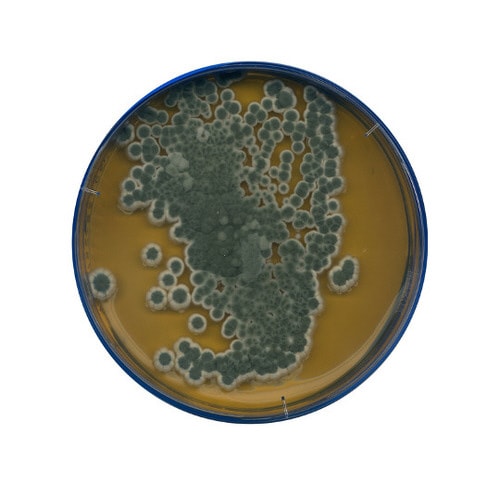
1.05398.0500 麦芽エキス寒天

分析/検査用品(その他)の売れ筋ランキング
- ¥6,820(税込) (税込)
- ¥2,244(税込) (税込)
- ¥13,794(税込) (税込) 〜
- ¥31,680(税込) (税込)
- ¥5,280(税込) (税込)
- ¥4,037(税込) (税込)
- ¥7,001(税込) (税込)
商品の特徴 |
Merckの「麦芽エキス寒天培地 微生物学用 105398 500G」は、品質と信頼性に優れた人気商品です。 |
|---|---|
商品仕様 |
|
メーカー情報 |
|
カタログ掲載ページ |
-/- |
| 注意事項 | ※【返品に関するご注意】この商品は直送品のため、お客様のご都合による返品はお受けできません。 |
|---|